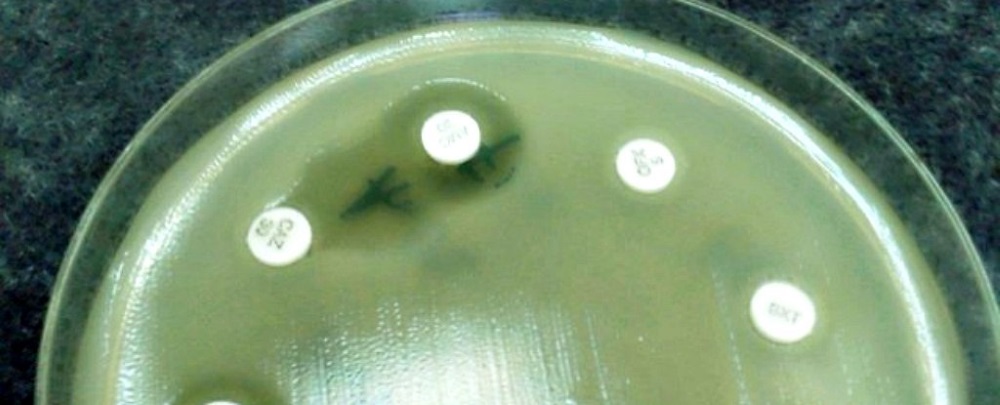

Cientistas desenvolveram uma molécula que reverte a resistência aos antibióticos em várias cepas de bactérias ao mesmo tempo, sendo um dos avanços mais promissores até agora na luta contra as superbactérias.
O anúncio não poderia vir em um momento melhor: na semana passada, pesquisadores relataram que uma mulher dos Estados Unidos foi morta por uma superbactéria resistente a todos antibióticos disponíveis, e que a resistência antibiótica está se espalhando mais rapidamente do que esperavam.
Mesmo as autoridades de saúde pública, conhecidas por sua abordagem calma diante de ameaças emergentes, estão apavoradas. Um relatório de 2014 previa que superbactérias matariam 300 milhões de pessoas em 2050, e as Nações Unidas declararam a questão uma “ameaça fundamental”.
O problema é que as infecções bacterianas que eram simples de lidar no passado – como pneumonia e gonorreia – estão evoluindo rapidamente, aumentando sua capacidade de sobreviver aos antibióticos existentes. A menos que existam novas opções de remédios em breve, é possível que fiquemos sem proteção contra elas. “Perdemos a capacidade de usar muitos de nossos principais antibióticos”, disse o pesquisador Bruce Geller da Oregon State University.
“Tudo é resistente a eles agora, só nos restou tentar desenvolver novas drogas para ficar um passo à frente das bactérias, mas quanto mais pesquisávamos, menos saídas apareciam”, acrescentou. “Restou-nos modificar os antibióticos existentes, mas assim que você faz uma mudança química, as bactérias se modificam geneticamente e ficam resistentes ao novo antibiótico quimicamente modificado”, completou.
Uma das maneiras pelas quais as bactérias propagam a resistência aos antibióticos é através de um gene que produz uma enzima conhecida como New Delhi Metallo-beta-lactamase (NDM-1). NDM-1 é preocupante porque torna as bactérias resistentes a uma classe de penicilinas chamadas carbapenemas, nosso último recurso de antibióticos.
“O significado da NDM-1 é que ela destrói carbapenemas, então os médicos tiveram que retirar um antibiótico, colistina, que não era usado há décadas porque é tóxico para os rins”, disse Geller. “Esse é literalmente o último antibiótico que pode ser usado em um organismo que expressa NDM-1, e agora temos bactérias que são completamente resistentes a todos os antibióticos conhecidos”, completou.
Para tentar lutar contra isso, Geller e seus colegas criaram uma molécula que ataca a NDM-1, e reverte a resistência aos antibióticos em muitas cepas diferentes de bactérias, o que significa que poderíamos ter uma chance de usar antibióticos novamente, que atualmente são inúteis contra as superbactérias.
A molécula é um tipo de PPMO, que significa peptídeo conjugado fosforamidato morfolino oligómero, e desativa NDM-1. Anteriormente, os pesquisadores haviam tentado usar PPMOs de ocorrência natural contra superbactérias, mas eles só trabalhavam em uma determinada cepa. Felizmente, a nova molécula é diferente.
“Estamos atingindo um mecanismo de resistência que é compartilhado por um grupo inteiro de patógenos”, disse Geller. “É o mesmo gene em diferentes tipos de bactérias, então você só tem que ter um PPMO que seja eficaz para todos eles, o que é diferente de outros PPMOs que são específicos para alguns gêneros”, completou.
A equipe testou o novo PPMO em três diferentes gêneros de bactérias em uma placa de Petri, sendo que todos expressaram NDM-1 e eram resistentes à carbapenema. Eles usaram a nova molécula ao lado de um tipo de carbapenema chamado meropeném, e mostraram que ele rapidamente restaurou a capacidade de matar as bactérias dos antibióticos.
Eles então usaram uma combinação do novo PPMO e meropeném em camundongos que estavam infectados com Escherichia coli (E. Coli) resistente a antibióticos, e mostraram que ela pôde efetivamente tratar a infecção e melhorar as taxas de sobrevivência dos ratos.
Isso sugere que, no futuro, o PPMO poderia ser usado juntamente com antibióticos existentes para tratar infecções de bactérias resistentes. “Um PPMO pode restaurar a susceptibilidade aos antibióticos que já foram aprovados, para que possamos obter um PPMO aprovado e, em seguida, voltar e usar esses antibióticos que se tornaram inúteis”, disse Geller.
Para ser claro, essa estratégia funcionar no laboratório e nos ratos não é prova suficiente de que ele vá trabalhar em seres humanos da mesma maneira, mas a equipe diz que a droga poderia estar pronta para ensaios clínicos nos próximos três anos.
A pesquisa foi publicada no periódico Journal of Antimicrobial Chemotherapy.
Fonte: (Jornal Ciência)